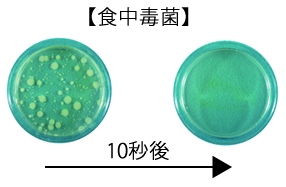
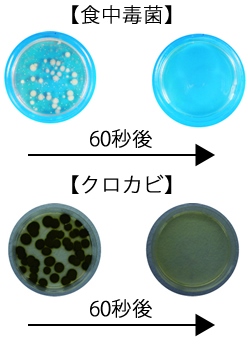

アルコールEA-75 【1斗缶】
ノロウイルス代替ウィルスを
99.99%以上除去できる効果のアルコール製剤
業務用アルコール EA-75 17L
食品添加物 エタノール製剤[ リンゴ酸 除菌剤 食品工場 ]
※こちらの商品は、代引き不可となっております。


「リンゴ酸」の優れた除去力に着目した新発想のアルコール製剤
安心・安全で環境にやさしい
- 安心・安全
成分のすべてが食品と食品添加物なので食品に触れても安心・安全に使えます。 - 環境に優しい
塩素系原料の安定性や、不安視される天然物原料や農薬、乳幼児に影響を及ぼす乳酸塩類等の食品添加物※を一切使用せず、環境に優しい製剤です
※平成25年5月15日厚生労働省より使用に関する注意喚起あり

除菌効果が高い
アルコールとリンゴ酸を安定エマルジョン化することで瞬時に菌の除去に使えます。

水廻りに強い
「水廻り」を意識した悪条件で、菌やカビの除去に使えます。

ウイルス対策に
ピンポイントにウイルス除去することで、対象物へのダメージがなく、ノロウィルス予防として有効な消毒剤※1として使えます。
※ネコカリシウイルスはノロウィルスの代替として、行政をはじめとした各機関において不活化試験に用いられる代替ウイルスです。

有機物汚れに強い
有機物汚れに強く、菌の除去にすばやく使えます。
| アルコールEA-75のメカニズム | ||
|---|---|---|
| 1:浸透性 | 2:乳化(エマルジョン) | 3:剥離 |
![]() |
![]() |
![]() |
| EA-75が菌のバイオフィルムや有機物汚れの内部に浸透 | 安定エマルジョン化でさらに菌や汚れの奥まで浸透 | 付着面を浮かばせて剥離し、菌が除去される |
| 一般のアルコールのメカニズム | |
|---|---|
| 1:付着 | 2:乾燥・凝固 |
![]() |
![]() |
| 菌の表面や有機物汚れ面に付着するが、すぐに乾燥 | 有機物汚れ面のタンパク質部分が凝固し菌が残る為、十分な効果を発揮できない |
消臭効果がある
トイレなどに多いニオイの原因となる「アンモニア」や、生臭いニオイの原因となる「メチルアミン」の悪臭物質に対して消臭効果を発揮します。

検証:自社調べ
マニュアルやガイドラインに対応
EA-75は、75度(73.1%)アルコール※2ですので、様々な行政等の推奨基準やマニュアル・ガイドラインに柔軟に使えます。
- 食品衛生法「大量調理施設衛生管理マニュアル※3」
- 「新型インフルエンザ対策ガイドライン※4」
- HACCPマニュアルの整備等
使用例 飲食店舗、食品工場、給食施設、介護施設、病院施設、教育施設、レジャー施設など
食品使用時の場合「酒精」、「アルコール」、「エタノール」、「エチルアルコール」と表記ください。
- ※1文部科学省スポーツ・青少年局学校健康教育課「調理場における洗浄・消毒マニュアルPart1」平成21年3月発行教材
- ※2危険物第4類アルコールに該当します。(市町村火災予防条例等については、各地方自治体にお問い合わせください。)
- ※3厚生労働省平成9年3月24日衛食第85号「大規模食中毒対策等について」別添(最終改正:平成25年2月1日付け食安発0201第代2号)
- ※4新型インフルエンザおよび鳥インフルエンザに関する関係省庁対策会議平成21年2月17日策定
- ※全ての菌に効く訳ではありません。
- お勧め商品
商品番号:152943631





